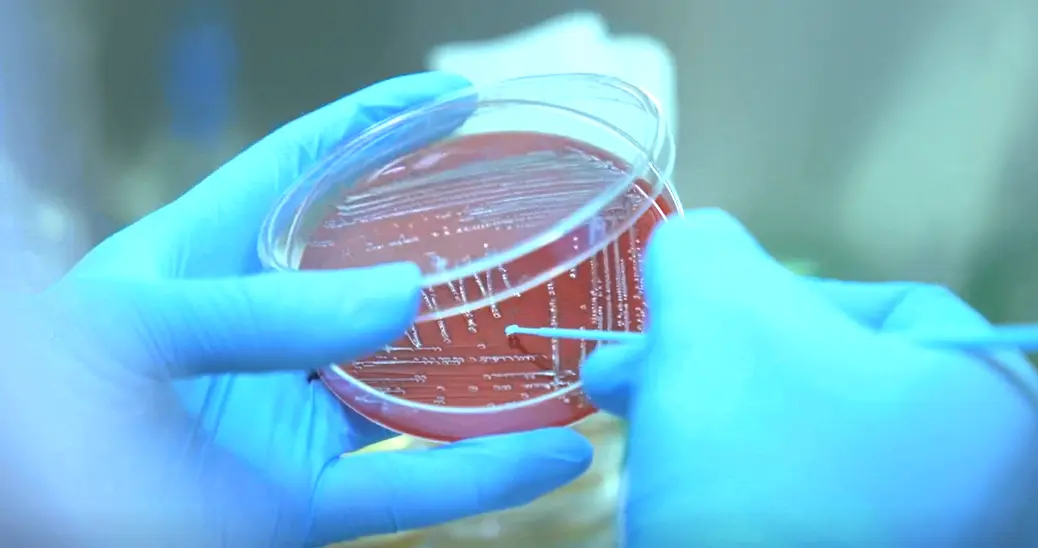
营养富集型平板
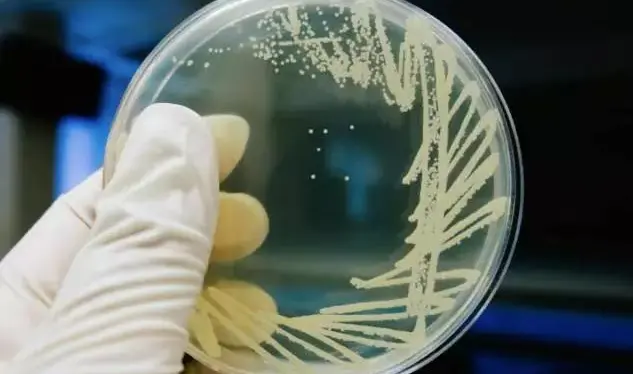
乳糖发酵鉴别平板

科研干货 | 从入门到精通:临床微生物鉴定平板核心特性详解
发布时间:2026-03-11 浏览次数:129
在临床微生物检测的科研与实操工作中,培养基平板是分离、鉴别病原微生物的核心工具,更是病原学诊断和后续药敏试验的重要基础。不同鉴定平板依托独特的选择性设计、营养配比及鉴别原理,能精准筛选目标菌株、有效区分杂菌,其特性掌握程度直接影响检测效率与鉴定准确性。
营养富集型平板:苛养菌分离的专属方案
苛养菌因生长对营养要求严苛,常规培养基无法满足其增殖条件,营养富集型平板通过针对性添加生长因子,成为该类菌株分离的核心载体,巧克力平板是临床最典型的应用代表。该平板的核心设计为补充 V 因子与 X 因子,两类因子是奈瑟菌属、嗜血杆菌属等苛养菌生长的必需营养成分,能实现此类菌株的高效分离与增殖。菌落形态上,目标苛养菌在巧克力平板上的菌落呈灰白色,质地湿润且为半透明状,无明显色素分泌与沉淀环形成,形态特征统一,便于科研与检测中的初步识别和挑取纯化。
肠道菌专用平板:强选择 + 双鉴别,精准筛致病菌
肠道致病菌与正常菌群的分离鉴别是临床微生物检测的重点方向,针对沙门氏菌、志贺氏菌等核心肠道致病菌,SS 琼脂、XLD 平板两款强选择性平板成为首选,二者均以抑制杂菌为基础,通过代谢产物差异实现目标菌株的精准区分。
SS 琼脂:硫化氢为核心鉴别指标
以强选择性抑制非目标菌生长,仅允许沙门氏菌与志贺氏菌增殖,同时依据菌株是否产生硫化氢完成二者鉴别。产硫化氢的沙门氏菌形成无色透明且带黑心的菌落;志贺氏菌为无色透明无黑心菌落;大肠埃希菌等杂菌形成桃红色菌落,常伴随胆盐沉淀环;变形杆菌虽也呈无色透明黑心菌落,但会形成更大的透明环,可与沙门氏菌明确区分。
XLD 平板:产碱特性 + 硫化氢双重鉴别
同样聚焦沙门氏菌与志贺氏菌的分离鉴定,鉴别逻辑结合产碱特性与硫化氢产生情况。产硫化氢的沙门氏菌菌落为红色或无色,且带有黑心;志贺氏菌为红色或无色无黑心菌落;大肠埃希菌因发酵特定碳源,在平板上形成特征性黄色菌落,杂菌识别特征显著,可快速完成肠道致病菌初筛。
乳糖发酵鉴别平板:凭发酵特性,分肠菌菌属
乳糖发酵能力是区分肠道菌属的关键生物学特征,以此为核心设计的乳糖发酵鉴别平板,通过抑制革兰氏阳性菌生长,结合乳糖发酵后的菌落颜色变化,实现目标菌株快速初筛。中国蓝、伊红美蓝、MAC 平板是临床常用款,三者在选择性强度与鉴别细节上各有侧重,适配不同检测需求。
中国蓝平板:弱选择,快速初筛首选
弱选择性设计,核心作用为抑制革兰氏阳性菌,仅通过乳糖发酵状态进行初筛。大肠埃希菌发酵乳糖形成蓝色菌落;痢疾志贺菌为淡红色菌落;鼠伤寒沙门菌与福氏志贺菌因不发酵乳糖,呈现无色透明菌落,整体筛选操作简单,适合大批量样本的快速初筛场景。
伊红美蓝平板:强选择,高辨识度鉴别
强选择性设计,对革兰氏阳性菌的抑制作用更强,鉴别精度更高。大肠埃希菌发酵乳糖后,菌落呈现带有金属光泽的蓝黑色或紫黑色,特征性极强;沙门氏菌与志贺氏菌则为无色透明菌落,杂菌与目标菌区分度显著,是肠道菌初筛的经典常用平板。
MAC 平板:中选择,分离纯化 + 初筛双适配
中等选择性设计,以胆盐为核心抑制成分,兼顾革兰氏阳性菌抑制与乳糖发酵鉴别。大肠埃希菌在平板上形成桃红色或红色菌落;沙门氏菌与志贺氏菌为无色透明菌落。其选择性与温和性达到平衡,既适合目标菌株的初筛,也可用于菌株的分离纯化,适配多场景检测需求。
弧菌专属平板:TCBS 平板,凭蔗糖发酵分种属
弧菌属是临床肠道与环境微生物检测的重要靶标,霍乱弧菌、副溶血性弧菌等致病性弧菌的快速分离,依赖弧菌专属的 TCBS平板,该平板为弧菌属的选择性分离量身设计,是弧菌检测的核心工具。TCBS 平板可实现弧菌属菌株的精准筛选,同时依据菌株的蔗糖发酵能力完成属内不同菌种的鉴别。霍乱弧菌能发酵蔗糖,在平板上形成黄色菌落;副溶血性弧菌无蔗糖发酵能力,菌落呈现蓝绿色,二者菌落颜色差异显著,无需额外生化试验即可完成初步区分,检测效率大幅提升。
特异性显色平板:酶底物反应,实现精准快速鉴定
随着微生物检测技术的发展,特异性显色平板依托酶底物反应等设计思路,突破传统筛选模式,实现单一靶标菌株或特定菌属的精准筛选与快速鉴定,大幅减少后续鉴定工作量,O157 显色平板与念珠菌显色平板是临床应用最广泛的两款产品。
O157 显色平板:大肠杆菌 O157:H7 的专属筛选
具有高度特异性,专为大肠杆菌 O157:H7 的筛选设计。目标菌株在平板上形成紫色或紫红色菌落;其他大肠杆菌菌株或杂菌则表现为蓝色、无色菌落,部分杂菌还会被平板直接抑制,可实现大肠杆菌 O157:H7 的一步式筛选,大幅提升检测精准度。
念珠菌显色平板:念珠菌属内的快速分种
基于酶底物反应原理,可实现念珠菌属内不同菌种的快速鉴定,无需复杂的生化试验。不同念珠菌在平板上呈现特征性颜色:白色念珠菌为翠绿色,热带念珠菌为铁蓝色,克柔念珠菌为粉红色,光滑念珠菌为淡紫色,其他酵母菌株则为白色或培养基本色,能快速完成念珠菌的初步菌种鉴定,适配临床快速诊断与科研菌株筛选场景。
本文由环凯转载自“医研学者”公众号,版权归原作者所有,仅供学习参考,如有侵权请联系删除!

